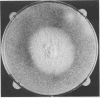

Abstract
Fusarium species are saprophytic molds and important plant pathogens, although they are increasingly recognized as agents of human mycosis. Frequently, the infection is superficial. Deep tissue infection may occur as an opportunistic hyalohyphomycosis, and wide dissemination is common in immunocompromised hosts. We describe a novel case of disseminated hyalohyphomycosis caused by F. napiforme in a patient with acute myelogenous leukemia. The clinical manifestations of this infection were similar to those attributed to infection with other species. In vitro susceptibility testing demonstrated resistance to amphotericin B and flucytosine, and progressive infection was documented until recovery of granulocyte function. The distinguishing clinical mycologic characteristics of this opportunistic mold are the unique turnip- or lemon-shaped microconidia. F. napiforme is a new agent of hyalohyphomycosis, further emphasizing the importance of Fusarium species as opportunistic molds.
Full text
PDF






Images in this article
Selected References
These references are in PubMed. This may not be the complete list of references from this article.
- Anaissie E., Kantarjian H., Jones P., Barlogie B., Luna M., Lopez-Berestein G., Bodey G. P. Fusarium. A newly recognized fungal pathogen in immunosuppressed patients. Cancer. 1986 Jun 1;57(11):2141–2145. doi: 10.1002/1097-0142(19860601)57:11<2141::aid-cncr2820571110>3.0.co;2-n. [DOI] [PubMed] [Google Scholar]
- Anaissie E., Kantarjian H., Ro J., Hopfer R., Rolston K., Fainstein V., Bodey G. The emerging role of Fusarium infections in patients with cancer. Medicine (Baltimore) 1988 Mar;67(2):77–83. doi: 10.1097/00005792-198803000-00001. [DOI] [PubMed] [Google Scholar]
- Barrios N. J., Kirkpatrick D. V., Murciano A., Stine K., Van Dyke R. B., Humbert J. R. Successful treatment of disseminated Fusarium infection in an immunocompromised child. Am J Pediatr Hematol Oncol. 1990 Fall;12(3):319–324. doi: 10.1097/00043426-199023000-00013. [DOI] [PubMed] [Google Scholar]
- Blazar B. R., Hurd D. D., Snover D. C., Alexander J. W., McGlave P. B. Invasive Fusarium infections in bone marrow transplant recipients. Am J Med. 1984 Oct;77(4):645–651. doi: 10.1016/0002-9343(84)90355-3. [DOI] [PubMed] [Google Scholar]
- Bruck H. M., Nash G., Stein J. M., Lindberg R. B. Studies on the occurrence and significance of yeasts and fungi in the burn wound. Ann Surg. 1972 Jul;176(1):108–110. doi: 10.1097/00000658-197207000-00019. [DOI] [PMC free article] [PubMed] [Google Scholar]
- Collins M. S., Rinaldi M. G. Cutaneous infection in man caused by Fusarium moniliforme. Sabouraudia. 1977 Jul;15(2):151–160. [PubMed] [Google Scholar]
- Gugnani H. C., Talwar R. S., Njoku-Obi A. N., Kodilinye H. C. Mycotic keratitis in Nigeria. A study of 21 cases. Br J Ophthalmol. 1976 Sep;60(9):607–613. doi: 10.1136/bjo.60.9.607. [DOI] [PMC free article] [PubMed] [Google Scholar]
- Helm T. N., Longworth D. L., Hall G. S., Bolwell B. J., Fernandez B., Tomecki K. J. Case report and review of resolved fusariosis. J Am Acad Dermatol. 1990 Aug;23(2 Pt 2):393–398. doi: 10.1016/0190-9622(90)70231-6. [DOI] [PubMed] [Google Scholar]
- Hiemenz J. W., Kennedy B., Kwon-Chung K. J. Invasive fusariosis associated with an injury by a stingray barb. J Med Vet Mycol. 1990;28(3):209–213. doi: 10.1080/02681219080000271. [DOI] [PubMed] [Google Scholar]
- Jakle C., Leek J. C., Olson D. A., Robbins D. L. Septic arthritis due to Fusarium solani. J Rheumatol. 1983 Feb;10(1):151–153. [PubMed] [Google Scholar]
- Jones D. B., Sexton R., Rebell G. Mycotic keratitis in South Florida: a review of thirty-nine cases. Trans Ophthalmol Soc U K. 1970;89:781–797. [PubMed] [Google Scholar]
- Jorens P. G., Van Den Heuvel P. A., Van Cauwelaert P. A., Parizel G. A., Mertens A. N. Fusarium endocarditis involving aortic valve following coronary artery surgery. Eur Heart J. 1990 May;11(5):476–478. doi: 10.1093/oxfordjournals.eurheartj.a059732. [DOI] [PubMed] [Google Scholar]
- Kerr C. M., Perfect J. R., Craven P. C., Jorgensen J. H., Drutz D. J., Shelburne J. D., Gallis H. A., Gutman R. A. Fungal peritonitis in patients on continuous ambulatory peritoneal dialysis. Ann Intern Med. 1983 Sep;99(3):334–336. doi: 10.7326/0003-4819-99-3-334. [DOI] [PubMed] [Google Scholar]
- Lupinetti F. M., Giller R. H., Trigg M. E. Operative treatment of Fusarium fungal infection of the lung. Ann Thorac Surg. 1990 Jun;49(6):991–992. doi: 10.1016/0003-4975(90)90885-a. [DOI] [PubMed] [Google Scholar]
- Merz W. G., Karp J. E., Hoagland M., Jett-Goheen M., Junkins J. M., Hood A. F. Diagnosis and successful treatment of fusariosis in the compromised host. J Infect Dis. 1988 Nov;158(5):1046–1055. doi: 10.1093/infdis/158.5.1046. [DOI] [PubMed] [Google Scholar]
- Minor R. L., Jr, Pfaller M. A., Gingrich R. D., Burns L. J. Disseminated Fusarium infections in patients following bone marrow transplantation. Bone Marrow Transplant. 1989 Nov;4(6):653–658. [PubMed] [Google Scholar]
- Nuovo M. A., Simmonds J. E., Chacho M. S., McKitrick J. C. Fusarium solani osteomyelitis with probable nosocomial spread. Am J Clin Pathol. 1988 Dec;90(6):738–741. doi: 10.1093/ajcp/90.6.738. [DOI] [PubMed] [Google Scholar]
- Richardson S. E., Bannatyne R. M., Summerbell R. C., Milliken J., Gold R., Weitzman S. S. Disseminated fusarial infection in the immunocompromised host. Rev Infect Dis. 1988 Nov-Dec;10(6):1171–1181. doi: 10.1093/clinids/10.6.1171. [DOI] [PubMed] [Google Scholar]
- Robertson M. J., Socinski M. A., Soiffer R. J., Finberg R. W., Wilson C., Anderson K. C., Bosserman L., Sang D. N., Salkin I. F., Ritz J. Successful treatment of disseminated Fusarium infection after autologous bone marrow transplantation for acute myeloid leukemia. Bone Marrow Transplant. 1991 Aug;8(2):143–145. [PubMed] [Google Scholar]
- Rush-Munro F. M., Black H., Dingley J. M. Onychomycosis caused by fusarium oxysporum. Australas J Dermatol. 1971 Apr;12(1):18–29. doi: 10.1111/j.1440-0960.1971.tb00688.x. [DOI] [PubMed] [Google Scholar]
- Steinberg G. K., Britt R. H., Enzmann D. R., Finlay J. L., Arvin A. M. Fusarium brain abscess. Case report. J Neurosurg. 1983 Apr;58(4):598–601. doi: 10.3171/jns.1983.58.4.0598. [DOI] [PubMed] [Google Scholar]
- Summerbell R. C., Richardson S. E., Kane J. Fusarium proliferatum as an agent of disseminated infection in an immunosuppressed patient. J Clin Microbiol. 1988 Jan;26(1):82–87. doi: 10.1128/jcm.26.1.82-87.1988. [DOI] [PMC free article] [PubMed] [Google Scholar]
- Valenstein P., Schell W. A. Primary intranasal Fusarium infection. Potential for confusion with rhinocerebral zygomycosis. Arch Pathol Lab Med. 1986 Aug;110(8):751–754. [PubMed] [Google Scholar]
- Veglia K. S., Marks V. J. Fusarium as a pathogen. A case report of Fusarium sepsis and review of the literature. J Am Acad Dermatol. 1987 Jan;16(1 Pt 2):260–263. [PubMed] [Google Scholar]
- Venditti M., Micozzi A., Gentile G., Polonelli L., Morace G., Bianco P., Avvisati G., Papa G., Martino P. Invasive Fusarium solani infections in patients with acute leukemia. Rev Infect Dis. 1988 May-Jun;10(3):653–660. doi: 10.1093/clinids/10.3.653. [DOI] [PubMed] [Google Scholar]
- Walsh T. J., Melcher G. P., Rinaldi M. G., Lecciones J., McGough D. A., Kelly P., Lee J., Callender D., Rubin M., Pizzo P. A. Trichosporon beigelii, an emerging pathogen resistant to amphotericin B. J Clin Microbiol. 1990 Jul;28(7):1616–1622. doi: 10.1128/jcm.28.7.1616-1622.1990. [DOI] [PMC free article] [PubMed] [Google Scholar]
- Wheeler M. S., McGinnis M. R., Schell W. A., Walker D. H. Fusarium infection in burned patients. Am J Clin Pathol. 1981 Mar;75(3):304–311. doi: 10.1093/ajcp/75.3.304. [DOI] [PubMed] [Google Scholar]
- Young C. N., Meyers A. M. Opportunistic fungal infection by Fusarium oxysporum in a renal transplant patient. Sabouraudia. 1979 Sep;17(3):219–223. [PubMed] [Google Scholar]